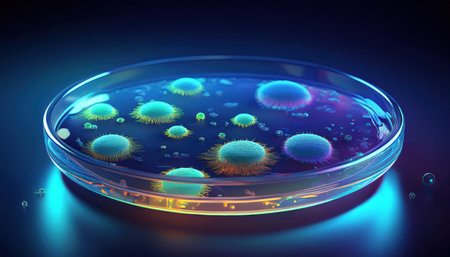
Vibrant microorganisms in a petri dish illuminate a high tech lab with swirling colors and bubbles.の素材

素材 - Vibrant microorganisms in a petri dish illuminate a high tech lab with swirling colors and bubbles.
作品情報
Vibrant microorganisms in a petri dish illuminate a high tech lab with swirling colors and bubbles.
- ID:248478426
- 作品種別:
- 作者名:lightfieldstudios
キーワード
- aigen
- aigenv
- aistudio
- analysis
- background
- biological
- biology
- biotechnology
- chemistry
- colors
- culture
- curiosity
- dark
- dish
- ecology
- environment
- experiment
- experimentation
- exploration
- facility
- fascinating
- fiction
- fluid
- forms
- growth
- health
- illustration
- innovation
- interaction
- laboratory
- life
- medical
- microorganisms
- microscopic
- microscopy
- observation
- organisms
- patterns
- petri
- research
- science
- scientific
- structures
- studies
- techniques
- transparent
類似作品
close-up of col...
Petri dish with...
This striking i...
close-up of sci...
Close up of col...
A cluster of va...
Microscopic vie...
Mixed of bacter...
Microscopic vie...
close-up of vib...
Colorful variet...
petri dish with...
3d illustration...
Close up of bac...
Digital art, il...
research biolog...
petri dish with...
close up of pet...
bacteria colony...
Close up of bac...
Microscopic mac...
petri dish fill...
Macro close-up ...
Top view of a p...
3d rendering of...
a close up imag...
Colorful variet...
Colorful variet...
Close-up of vir...
Microorganisms ...
Macro close up ...
3d rendering. M...
Abstract cell h...
Close-up of a s...
Close up of bac...
High resolution...
Vibrant yellow ...
petri dish with...
Close up of pet...
Microscopic vie...
Bacteria, micro...
A petri dish wi...
a close up of c...
Backgrounds of ...
This vivid abst...
microbial cultu...
Bacteria colony...
microbial cultu...
Close up of bac...